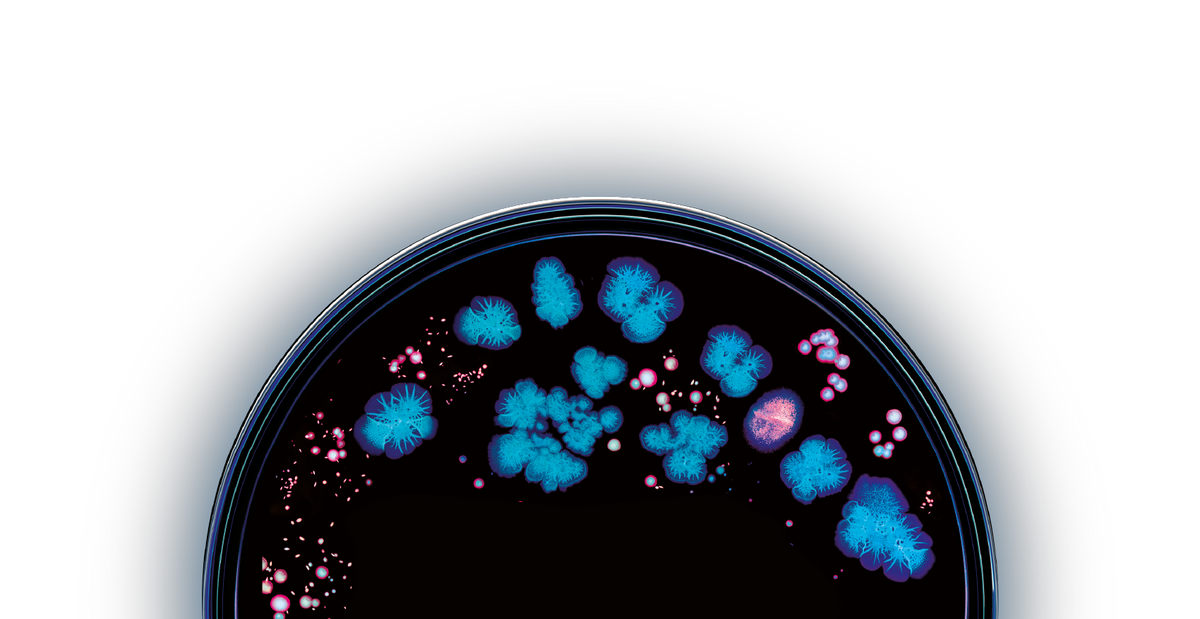
We address root causes, not quick fixes background image

FSA/HSA Eligible. Free Shipping, Always.
All our cutting-edge sequencing technology, research, and processing is in the pursuit of simple, actionable recommendations that anyone can take to better their health.
Your sample is processed by the premier microbiome analysis lab in the country. Once your microbiome is analyzed, Jona’s artificial intelligence technology compares your microbiome against 60,000 scientific, peer-reviewed medical papers to find associations between your microbiome and diseases, conditions, symptoms and the actions you can take to be most effective.

We’re partners with the world’s leaders in microbiome science, digestive health, and AI technology to bring you the best product possible.











Join us in shaping the future of microbiome science as we evolve into a healthier species.